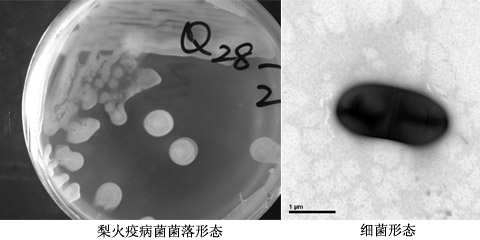
梨火疫病

梨树火疫病

梨树火疫病如何防治梨树火疫病用什么药
图片尺寸537x370梨火疫病
图片尺寸960x1280梨火疫病
图片尺寸900x802梨火疫病
图片尺寸681x1024梨火疫病
图片尺寸960x1280
动植物检疫梨火疫病菌知多少
图片尺寸539x363梨火疫病
图片尺寸1000x750
种植梨如何防治梨树疫病
图片尺寸620x452
这棵梨树得的是什么病,有什么方法可以医治
图片尺寸600x450
梨火疫病.李志红 摄
图片尺寸2048x1280亚洲梨火疫病
图片尺寸495x322梨火疫病
图片尺寸2304x1801
梨树.请问各位老师这是什么病,怎么处理呢?
图片尺寸864x1152
动植物检疫梨火疫病菌知多少
图片尺寸301x400
这是梨树的什么病害大家讨论讨论
图片尺寸768x1024
梨树,苹果树火烧病防治措施
图片尺寸530x707
各位老师看看梨树得什么病了?
图片尺寸612x816梨火疫病
图片尺寸480x240亚洲梨火疫病
图片尺寸457x341
梨树 生病
图片尺寸1280x960